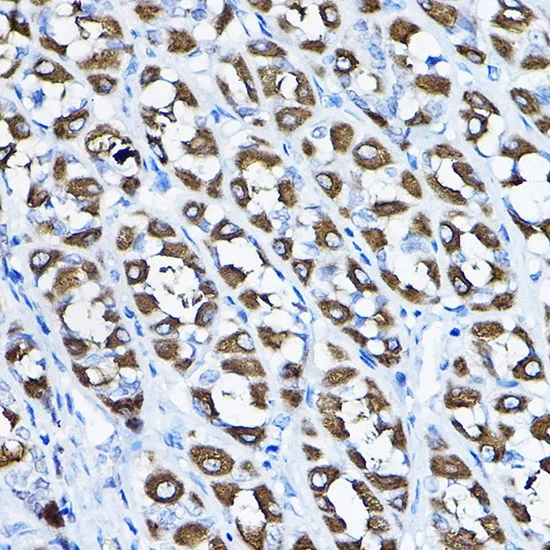

WB analysis of various sample lysates using GTX33407 PGLS antibody. Dilution : 1:1000 Loading : 25microg per lane
PGLS antibody
GTX33407
ApplicationsWestern Blot, ImmunoHistoChemistry, ImmunoHistoChemistry Paraffin
Product group Antibodies
TargetPGLS
Overview
- SupplierGeneTex
- Product NamePGLS antibody
- Delivery Days Customer9
- Application Supplier NoteWB: 1:500 - 1:2000. IHC-P: 1:50 - 1:200. *Optimal dilutions/concentrations should be determined by the researcher.Not tested in other applications.
- ApplicationsWestern Blot, ImmunoHistoChemistry, ImmunoHistoChemistry Paraffin
- CertificationResearch Use Only
- ClonalityPolyclonal
- ConjugateUnconjugated
- Gene ID25796
- Target namePGLS
- Target description6-phosphogluconolactonase
- Target synonyms6PGL, HEL-S-304, 6-phosphogluconolactonase, epididymis secretory protein Li 304, epididymis secretory sperm binding protein
- HostRabbit
- IsotypeIgG
- Storage Instruction-20°C or -80°C,2°C to 8°C
- UNSPSC12352203